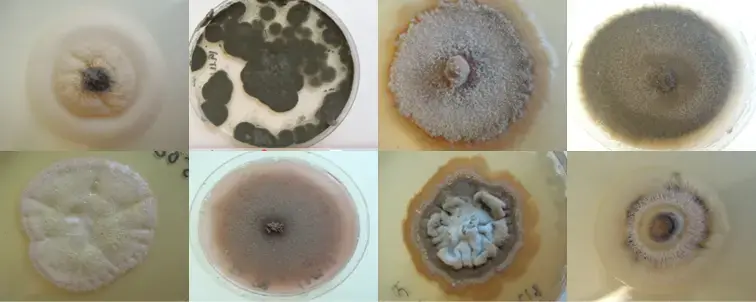

Kva ser du her?
- 1/1
På biletet over kan du sjå ein type sopp som finnast mange stadar i norsk natur, som på Mangersneset, Hosteland, Dyrkolbotn, Vardetangen, Kræmmerholmen, Brøknipa, Stolmen og Årvikmarka. Likevel har du truleg aldri sett dennetypen sopp før. Den er nemlig mikroskopisk liten, og lev stort sett nede i jorda. For å ta bileta du ser over har forskarar fått den til å formeire seg i små plasskåler heilt til det er så mykje av den at ein kan sjå den med det blotte auge.
Desse soppane er mychorriza-soppar, det vil seie soppar som formar sopprot saman med plantar. Ei sopprot er eit samarbeidsprosjekt mellom ein plante og ein sopp, der soppen samlar næringsstoff som planta treng frå jorda og leverer det til planta gjennom planterøtene I betaling får soppen sukker frå planta sin fotosyntese.
Det finst mange mycorrhizasoppar, og mange av dei vanlege soppane våre er faktisk slike - til dømes kantarellen. Kantarellen er ein type mychorriza-sopp vi lett kan sjå - ei lita stund på seinsommaren og tidleg haust. Resten av året lev kantarellane som små, mikroskopiske soppar nede i jorda. Soppane på biletet over er ein anna type mycorrhizasopp, som aldri blir til store soppar over bakken. Vidare har dei til likskap at dei samarbeidar med plantar i lyngfamilien, som blåbær, tyttebær og røsslyng. Sjølv om dei nok er ganske vanlege i naturen vår har dei ikkje fått norske namn, så vi må omtale dei med sine latinske namn. Fordi mange soppar kan vere vanskelege å oppdage og studere er det mykje vi ikkje veit om dei, og mange artar har vi enno ikkje oppdaga. Likevel er dei ein viktig del av naturmangfaldet vårt, og dei bidreg til at naturen fungerer.
Neste gong du er ute og går i naturen kan du tenke på at i jorda under skoa dine er det eit rikt liv, sjølv om du ikkje kan sjå det.